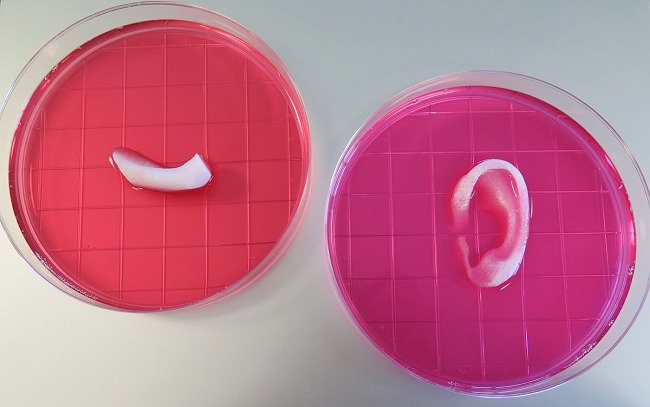

Il team di esperti guidato dal professor Anthony Atala, già ampiamente noto per i suoi tanti esperimenti sull’argomento, pubblicati anche sulla rivista Nature ha comunicato di aver raggiunto un importante traguardo.
Presso l’Istituto di medicina rigenerativa Wake Forest (Stati Uniti), Atala insieme con i suoi collaboratori hanno messo a punto una stampante 3D capace di ricreare tessuti umani.
I materiali stampati, stando ai risultati dei test condotti su topi di laboratorio, sarebbero eccezionali perché permetterebbero di replicare strutture del corpo umano azzerando ogni possibilità di necrosi.
L’Integrated Organ and Printing System (ITOP) svelato dai ricercatori statunitensi è una sorta di stampante 3D che usa materiale biodegradabili, simili alla plastica che possono essere plasmati a proprio piacimento per formare tessuti umani.
La stampante 3D usa soluzioni acquose contenenti anche cellule umane e permette di ricreare quei microcanali che consentono il passaggio dell’ossigeno e delle sostanze nutritive.

Certo, per anni si è parlato di materiali che possono essere impiantati chirurgicamente previa stampa tridimensionale. L’annuncio del team di Atala, però, è rilevante per tutta una serie di motivi: in primis, i tessuti stampati in 3D con il sistema ITOP che sono stati usati sui topi di laboratorio hanno evidenziato risultati eccellenti: in pochi mesi si è registrata la formazione di cartilagine e di vasi sanguigni. Ottimi risultati si sono registrati anche con l’utilizzo di strutture ossee create con la medesima stampante tridimensionale.
Dovrebbe quindi mancare poco all’avvio dei primi test su persone in carne ed ossa.
/https://www.ilsoftware.it/app/uploads/2023/05/img_13417.jpg)
/https://www.ilsoftware.it/app/uploads/2026/05/collaborazione-office-mail-azienda-nas-ds1825plus-synology.jpg)
/https://www.ilsoftware.it/app/uploads/2026/05/googlebook-qualcomm-snapdragon-AI.jpg)
/https://www.ilsoftware.it/app/uploads/2026/05/qualita-driver-windows-11-batteria-prestazioni.jpg)
/https://www.ilsoftware.it/app/uploads/2025/04/ARM-chip-cpu-data-center.jpg)